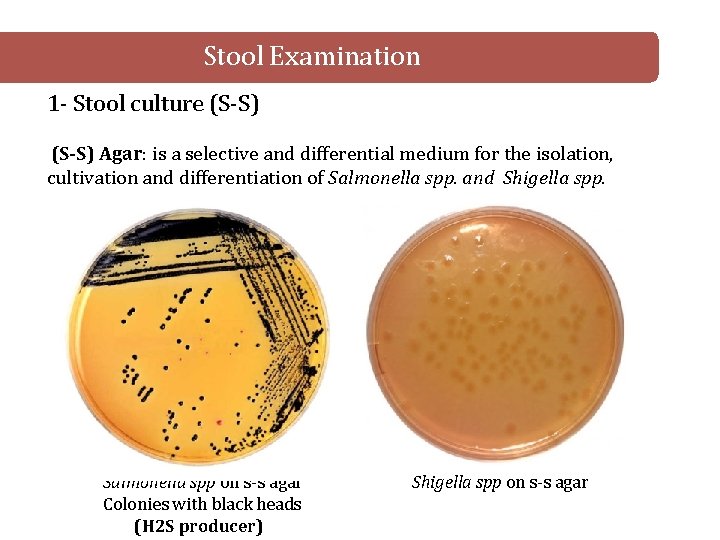
Stool Examination 1 - Stool culture (S-S) Agar: is a selective and differential medium

GastroIntestinal Tract System Instructor Noor AlSaleh Introduction Stool

- Slides: 22
Gastro-Intestinal Tract System Instructor : Noor Al-Saleh
Introduction Stool Examination for GIT infections: 1) Stool culture, to identify Bacteria 2) Fecal wet mount, to identify Parasites
Stool Examination 1 - Stool culture (S-S) Agar: is a selective and differential medium for the isolation, cultivation and differentiation of Salmonella spp. and Shigella spp. Salmonella spp on s-s agar Colonies with black heads (H 2 S producer) Shigella spp on s-s agar
Stool Examination 2 -Fecal wet mount preparation: GI infections by parasites are primarily diagnosed by: 1 - Cysts 4 - Helminth eggs 2 - Trophozites 5 - Helminth larva 3 - Oocysts 6 - Occasionally adults worms/segments Ø Saline wet mount: -demonstrates: eggs, larvae, trophozoites, cysts, RBCs and WBCs -detects motility of alive trophozites Ø Lugol’s Iodine wet mount: -stains nuclei and intra-cytoplasmic organelles üOnce Iodine is added, the organism will be killed and motility will be lost
Stool Examination 2 -Fecal wet mount preparation: 1 - Place one drop of saline/Iodine on different slides 2 - Dissolve small amount of stool (size=match head) in each drop, mix 3 - place cover slip (avoid air bubbles) 4 - Examine under 10 X then 40 X objective lens üThe mount should be just thick that newspaper print can be read through the slide
Parasite Identification Ø Intestinal protozoa: (unicellular) - Rhaizopode: Entamoeba histolytica - Flagellate: Giardia lamblia - Ciliates: Balantidium coli
Entamoeba histolytica - Trophozoite ØProgressive and directional motility by pseudopodium Ø Nucleus: 1 N with fine evenly distributed membrane chromatin and small central karyosome Ø Cytoplasm: contains ingested RBCs (erythrophagocytosis) Ø Disease: Amoebic Dysentery Ø Diagnostic stage: Trophozoites or cysts in stool specimen
Entamoeba histolytica - Trophozoite
Entamoeba histolytica - Cyst Ø Round shape Ø non-motile Ø Infective stage Ø Nucleus: 1 N or 2 N or 4 N Ø Cytoplasm: may contains chromatoidal bars and glycogen vacuoles
Giardia lamblia - Trophozoite Ø Pear shaped Ø Falling leaf movement (erratic) Ø Nucleus: 2 N with giant karyosome, no membrane chromatin Ø Sucking disk: for attachment Ø 8 Flagella Ø Axonemes: gives rigidity Ø 2 Median bodies: composed of microtubules
Giardia lamblia - Trophozoite
Giardia lamblia - Cyst Ø Oval shape ØInfective stage Ø Nucleus: 4 N Ø Axonemes present Ø 2 or 4 Median bodies ØDisease: Giardiasis (Traveler’s Diarrhea) Ø Diagnostic stage: Trophozoites or cysts in stool specimen
Balantidium coli - Trophozoite ü The only ciliate to infect humans Ø Oval shape Ø Nucleus: 2 N üMacronucleus (kidney shape) üMicronucleus Ø Cytoplasm: Food and contractile vacuoles Ø Funnel-like cytostome (mouth-like) Ø Covered with cilia
Balantidium coli - Cyst Ø Oval or spherical shape ØInfective stage Ø Macronucleus Ø Thick cyst wall with 1 or 2 layers ØDisease: Balantidiasis Ø Diagnostic stage: Trophozoites or cysts in stool specimen
Parasite Identification Ø Helminthes-Worms: (multicellular) - Cestodes (Flat worms): Tapeworms - Taenia saginata - Nematodes (Round worm): = Ascaris – Acaris lumbricoides = Hook worms - Ancylostoma duodenale / Necator americanus = Pin worm - Enterobius vermicularis = Whip worm - Trichuris trichura
Cestodes - Taenia saginata Disease: Taeniasis Diagnostic stage: A- usually by finding the ova/eggs in stool B- finding the gravid proglottid in stool Ova/egg features: 1 - Sepherical or slightly oval 2 - radially-striated 3 - The internal oncosphere contains 6 refractile hooks (hexacanth emryo)
Cestodes - Taenia saginata Gravid proglottid: very mature segment found posteriorly, contains uterus filled with eggs, occasionally seen in stool
Nematodes - Ascaris lumbricoides -The most common human helminthic infection -Largest intestinal nematode Disease: Ascariasis Diagnostic stage: A- fertilized and unfertilized eggs in stool B- adult worms in stool (rarely) Ova/egg features: 1 -fertilized egg: rounded, thick shell with external mammillated layer 2 - unfertilized egg: oval, thin shell with more variable mammillated layer, larger than the fertilized egg, contains a mass of retractile granules
Nematodes - Ascaris lumbricoides
Nematodes - Hookworms 1 - Ancylostoma duodenale “old world hookworm” Ancylostomiasis 2 - Necator americanus “ new world hookworm” Necatoriasis Diagnostic stage: Finding eggs in stool Ova/egg features: - The eggs of Ancylostoma duodenale and Necator americanus can’t be differentiated microscopically - Eggs are colorless, thin-shelled
Nematodes (Pin worm) - Enterobius vermicularis Disease: Entrobiasis Diagnostic stage: 1 - eggs collected from perianal area by “Scotch test” Eggs not commonly found in stool 2 - adult worms from perianal area or in stool Ova/egg features: “D” shaped, elongated-oval slightly flattened on one side Photo credit: Mohammad Muneer – Passion Batch
Nematodes (Whip worm) - Trichuris trichura Diagnostic stage: Finding unembryonated eggs in stool Ova/egg features: Lemon-shaped, thick-shelled with pair of polar plugs